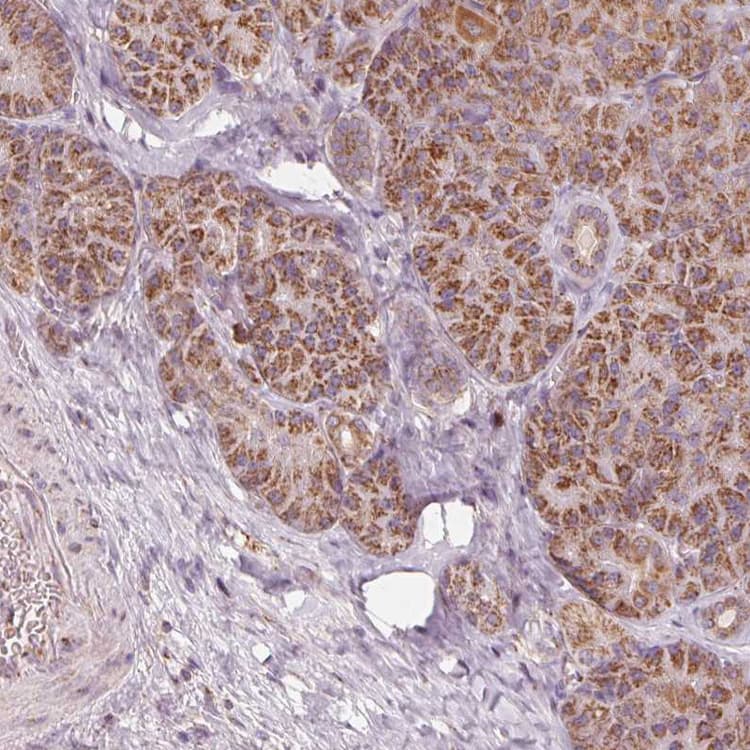

Anti-TOM70 antibody(ab251925)
$undefined

Rabbit Polyclonal TOM70 antibody. Suitable for IHC-P, WB, ICC/IF and reacts with Human samples. Cited in 1 publication. Immunogen corresponding to Recombinant Fragment Protein within Human TOMM70 aa 100-300.
| Shipped At Conditions | Blue Ice |
| Appropriate Long term Storage Conditions | Store at -20°C. |
| Clonality | Polyclonal |
| Applications | ICC/IF, IHC-P, WB |
| Species Reactivity | Human |
| Isotype | IgG |